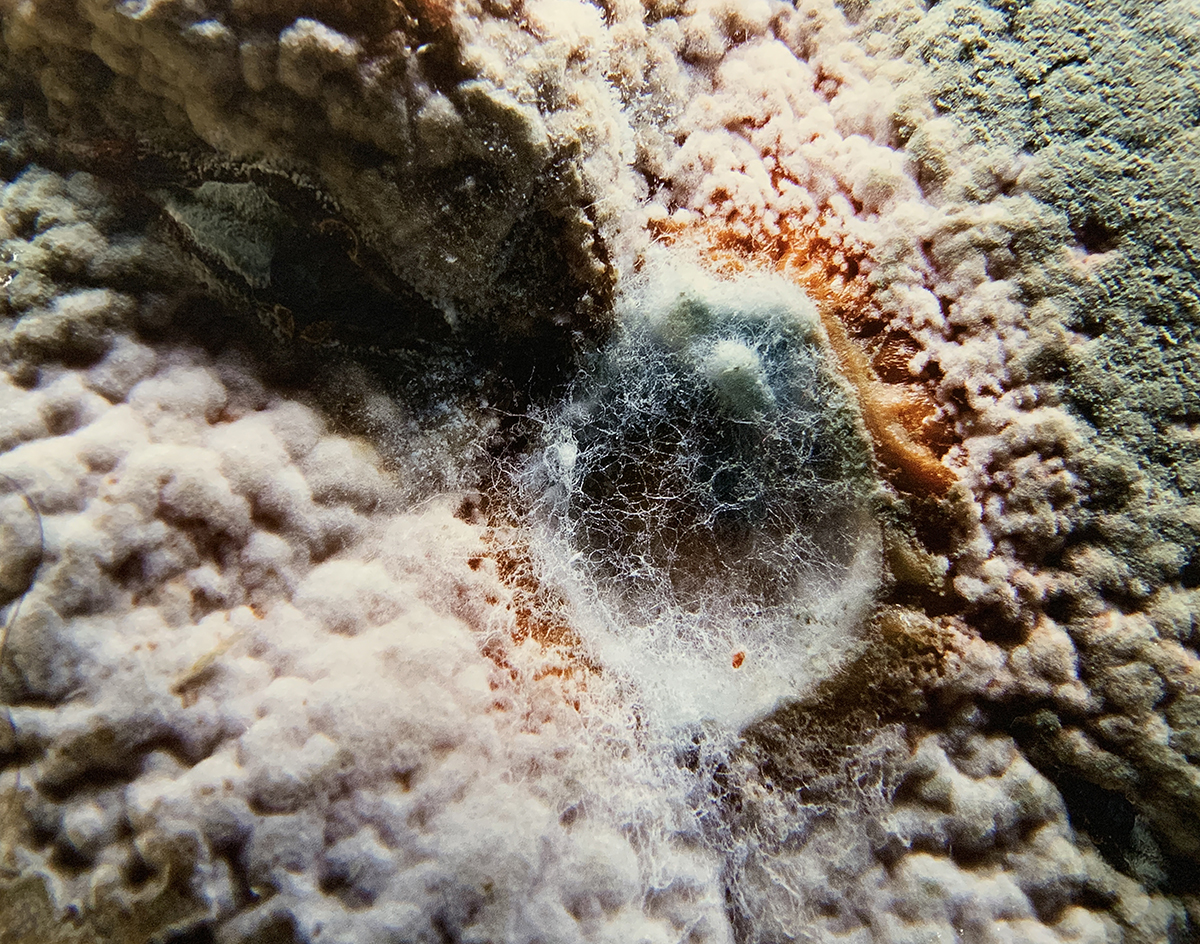

Que Zaragoza está viviendo un momento cultural muy rico y agitado es una realidad como podemos comprobar con la apertura de nuevos espacios culturales, nuevos negocios creativos, exposiciones, presentaciones y una larga oferta creativa y cultural. Pero, por si esto fuera poco, hace unos días se celebró la apertura de un nuevo espacio creativo, el Espacio Moos. Un lugar que nace para enriquecer la oferta creativa y ser un referente cultural en el ecosistema creativo de la ciudad que, y ya adelantamos que va a dar mucho que hablar en nuestra querida Zaragoza.

El Espacio Moos abrió sus puertas el pasado sábado 15 de abril en el número 50 de la Calle Borja, en pleno centro del popular barrio de Delicias, una zona que está experimentando una profunda transformación gracias al proyecto de innovación comercial «Paseos comerciales» y a la creación de nuevos negocios creativos en la zona. De hecho, en esta misma calle, nos encontramos el taller de moda ética Shiwa (en el número 45-47).
Para la inauguración del nuevo Espacio Moos, sus impulsores nos propusieron vivir una jornada repleta de actividades (exposición de Mooses y performance de Carlos Fortuna aka La Fortuna), amigos y una sesión musical a cargo de DJ Mr. Bigshot y DJ Monkey Loops, todo ello para presentar sus servicios culturales y adelantar parte de todo lo que va a suceder en este lugar. El espacio, de carácter híbrido, cuenta con varias zonas de actividad: zona de exposiciones, zona de taller para creación de obra y una zona de actividades didácticas para realizar cursos, talleres y presentaciones. Pero, además de su propia programación, el espacio está abierto para colaborar con otras iniciativas y se puede reservar para eventos y actividades.
El proyecto pinta muy bien pero ¿Quién está detrás de esta iniciativa?
Julsen Moos y Carlos Lafuente Tomás, los creadores del Espacio Moos.
Tras el espacio Moos, encontramos a Julsen Moos y Carlos Lafuente Tomás, dos caras ya conocidas dentro de la economía creativa y la cultura local. Julsen fue creadora e impulsora -junto a Patrick- del taller Moosesbildwerk, un taller profesional de impresión de alta calidad que se ha ganado un puesto muy relevante dentro del sector por su gran solvencia técnica y la calidad de su trabajo. Julsen estudió Ilustración y Escultura en la Escuela de Arte de Zaragoza y se dedica de forma profesional al arte, el diseño y la ilustración.

Por su parte, Carlos Lafuente Tomás estudió un Grado Superior de Artes aplicadas a la Escultura en la Escuela de Arte de Zaragoza. Es artista y creativo que ha desarrollado también una faceta profesional en el sector de la economía creativa y que ahora, junto a Julsen, llega con muchas ganas de trabajar en su nuevo espacio y hacer de su local un espacio de referencia para la ciudad.
Mooses, exposición inaugural de lujo.
Yo creo que la fotografía me ha dado más que yo a ella.
Mooses

El Espacio Mooses no puede comenzar mejor ya que, para la exposición inaugural con la que abre el espacio expositivo, cuenta con una selección de obras del fotógrafo Rudolf Mooses, padre de Julsen y maravilloso artista. Mooses (Innsbruck, 1950) fue un fotógrafo que dedicó más de cuarenta años en varios países europeos principalmente a la fotografía en sus múltiples vertientes: fue fotógrafo comercial, artista con obra propia, director artístico de la sala PRO40, profesor en Spectrum Sotos, positivador e impresor. Desde 1982, se instaló en Zaragoza donde decidió quedarse hasta el final de su vida y donde desarrolló una gran obra fotográfica.
Una selección de su obra se exhibe ahora en este nuevo espacio, a modo de homenaje. A través de esta muestra, podemos acercarnos un poco más a la ingente creación de Mooses, un artista que fue un auténtico experto en la aplicación de las nuevas tecnologías a la técnica fotográfica.



Desde Made in Zaragoza, damos la enhorabuena a Julsen y Carlos por esta iniciativa de la que estamos seguros que dará mucho que hablar y se convertirá en un referente para la ciudad. Así que si quieres conocerlo más en profundidad, tiene las puertas abiertas y te está esperando en el número 50 de la calle Borja. ¡Seguro que te va a encantar




